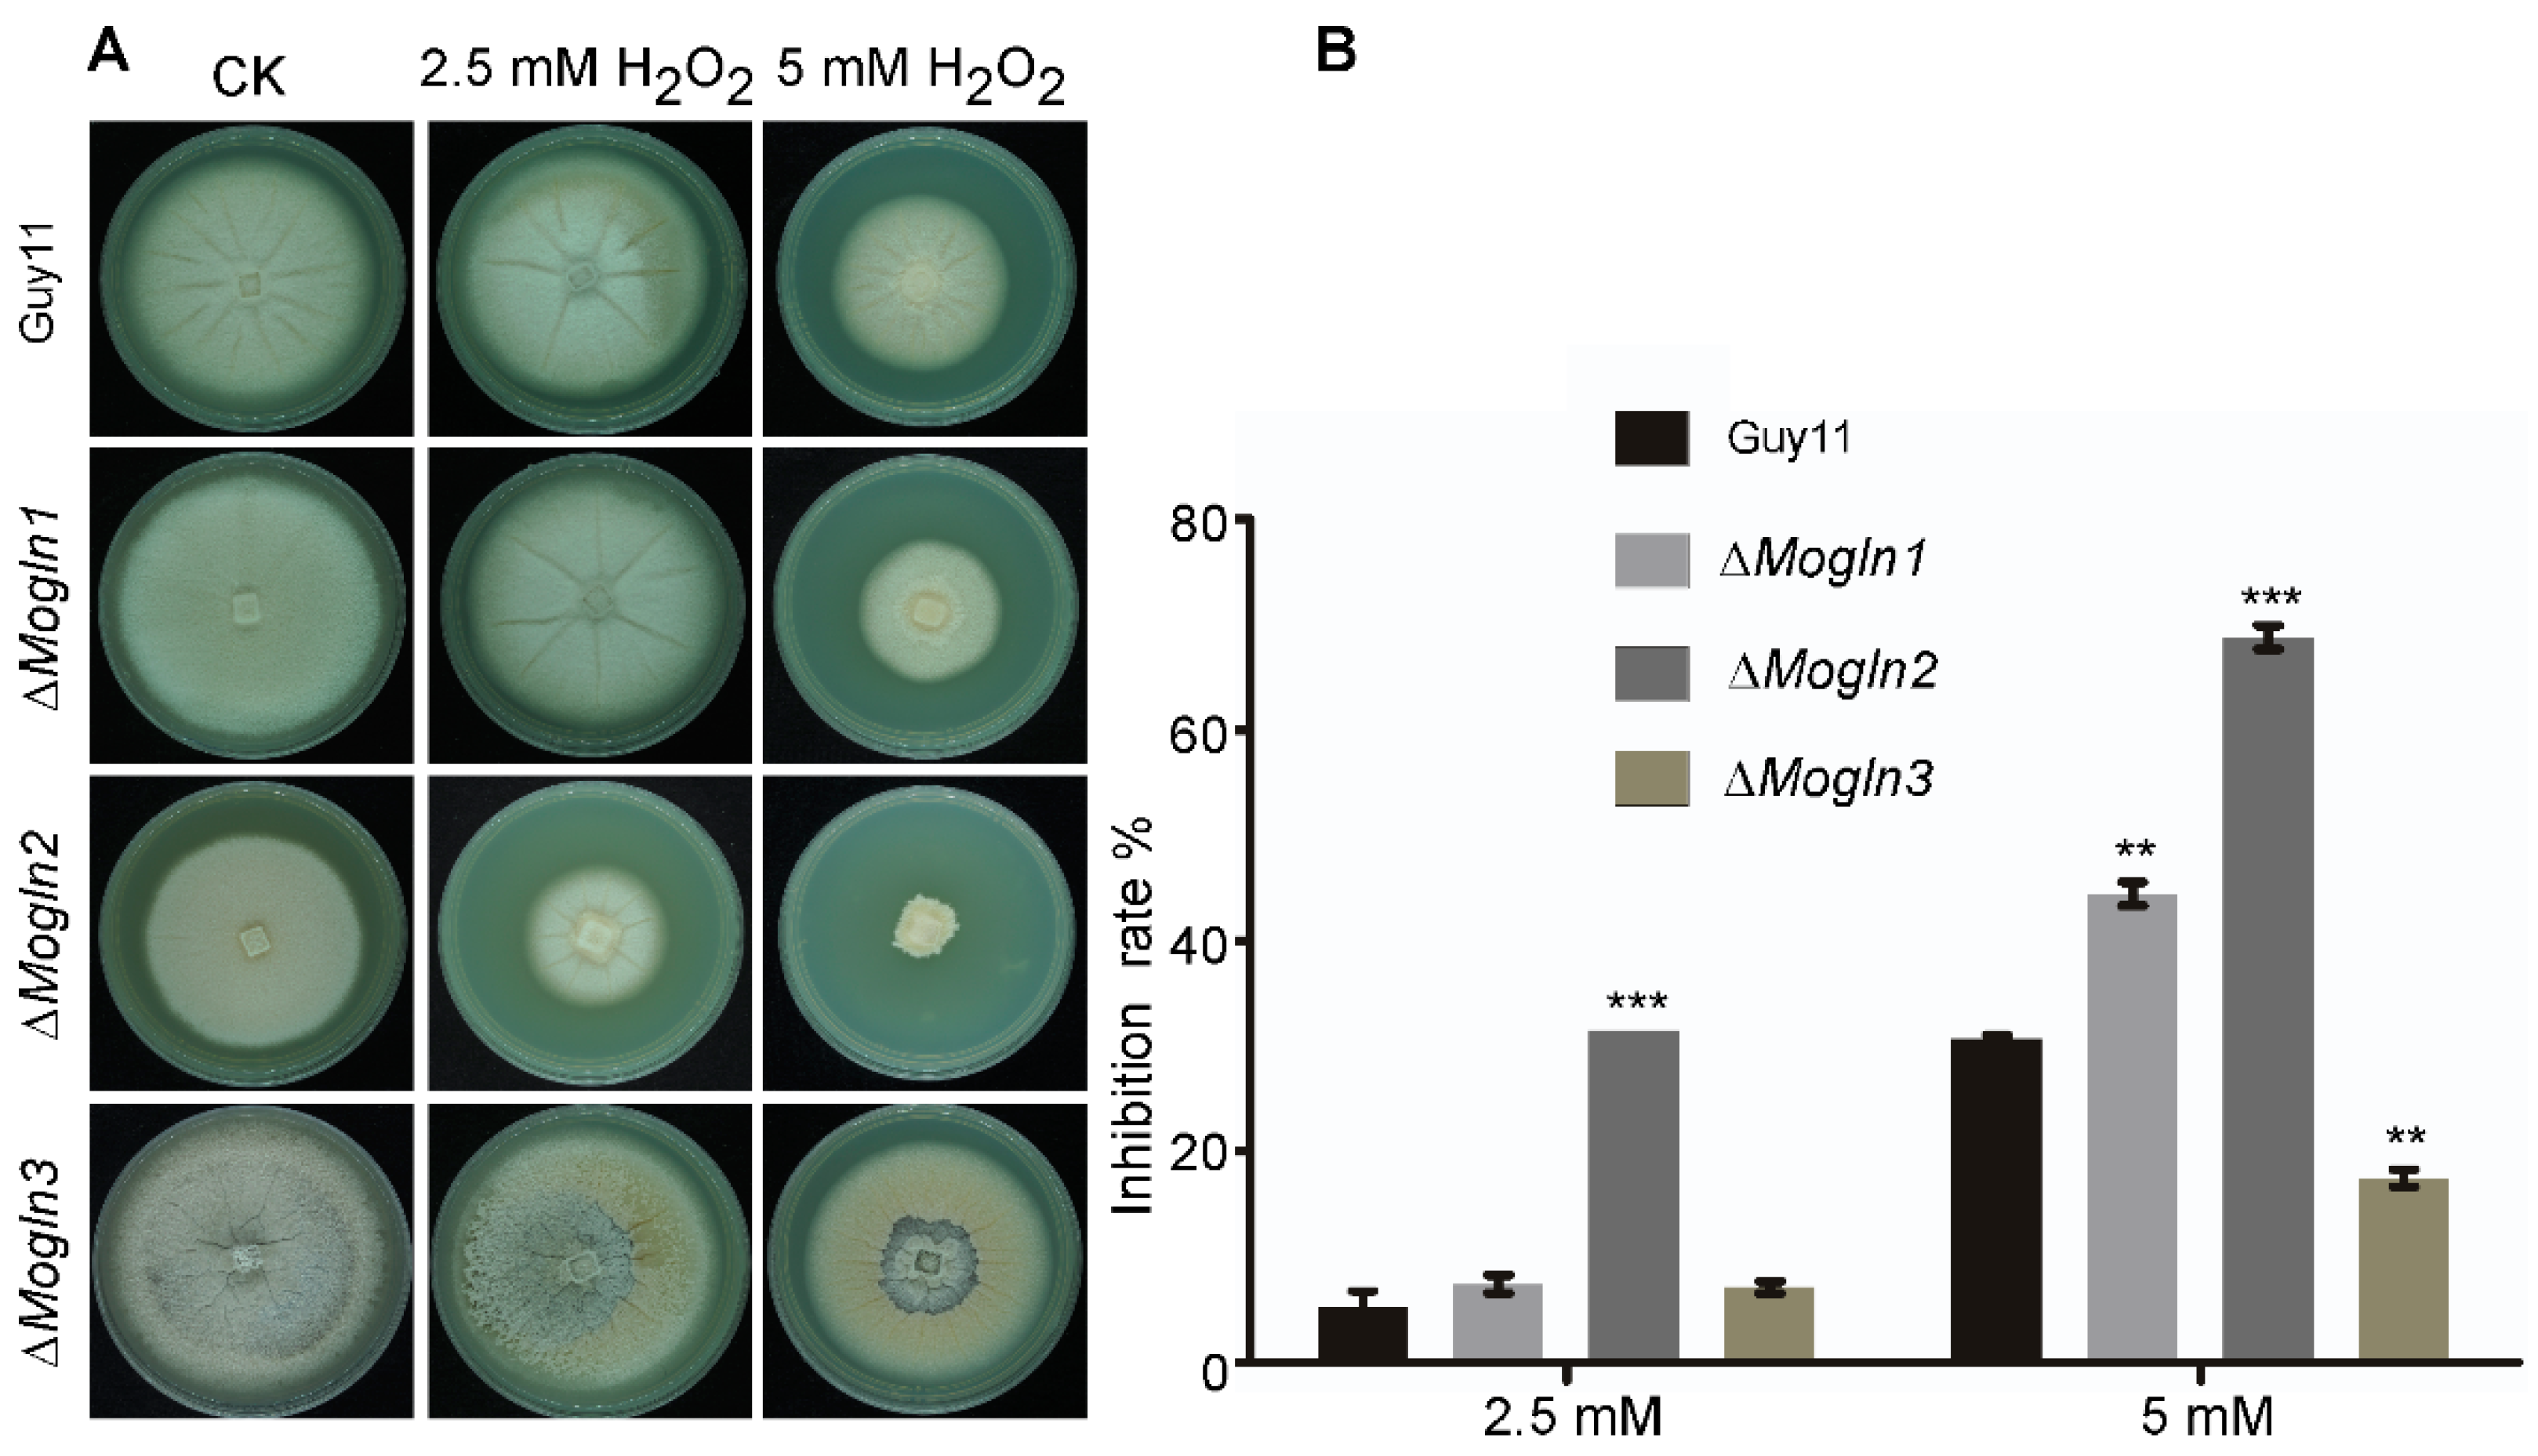

MoGLN2 Is Important for Vegetative Growth, Conidiogenesis, Maintenance of Cell Wall Integrity and Pathogenesis of Magnaporthe oryzae
Abstract
1. Introduction
2. Materials and Methods
2.1. Fungal Strains and Culture Conditions
2.2. Target Gene Deletion and Complementation in M. oryzae
2.3. Appressorium Formation, Penetration, and Infection Assays
2.4. Nucleic Acid Manipulation, Southern Blotting Analysis, and qRT-PCR
2.5. Western Blot Assays
2.6. RNA Isolation, Library Construction, and Sequencing
- i.
- a minimum 2-fold difference in gene expression between the control Guy11 and the ΔMogln2 (|log2FC| > 1);
- ii.
- a maximum false discovery rate (FDR) of 0.01 (FDR < 0.01).
2.7. High-Performance Liquid Chromatography (HPLC) Assays
2.8. Microscopy
2.9. Bioinformatic Analysis
3. Results
3.1. Identification of Glutamine Synthetase in M. oryzae
3.2. Expression of MoGLN Genes at Different Developmental Stages of M. oryzae
3.3. Generation of ΔMogln1, ΔMogln2, and ΔMogln3 Deletion Strains
3.4. MoGLN2 Contributes to Vegetative Growth in M. oryzae
3.5. Glutamine Auxotroph in Rice Blast Fungus Occurs via Inactivation of MoGLN2
3.6. MoGLN2 Is Required for Asexual Reproduction in M. oryzae
3.7. MoGLN2 Is Important for Appressorium Formation in M. oryzae
3.8. MoGLN2 Is Essential for Full Virulence in M. oryzae
3.9. MoGLN1 and MoGLN3 Are Not Involved in Appressorium Penetration and Infectious Hyphal Growth
3.10. Cell Wall Integrity Is Impaired in the ΔMogln2 Deletion Mutant
3.11. Intracellular Levels of Other Amino Acids Were Higher in ΔMogln2 Mutant
3.12. ΔMogln2 Is Hypersensitive to Oxidative Stress
3.13. MoGLN2 Is Important for Melanin Biosynthesis in Rice Blast Fungus
3.14. Differentially Expressed in ΔMogln2 Mutant
3.15. Subcelullar Localization of MoGLN Genes
4. Discussion
Supplementary Materials
Author Contributions
Funding
Institutional Review Board Statement
Informed Consent Statement
Data Availability Statement
Acknowledgments
Conflicts of Interest
References
- Cooper, A.J.; Jeitner, T.M. Central role of glutamate metabolism in the maintenance of nitrogen homeostasis in normal and hyperammonemic brain. Biomolecules 2016, 6, 16. [Google Scholar] [CrossRef]
- Curi, R.; Lagranha, C.J.; Doi, S.Q.; Sellitti, D.; Procópio, J.; Pithon-Curi, T.C.; Corless, M.; Newsholme, P. Molecular mechanisms of glutamine action. J. Cell. Physiol. 2005, 204, 392–401. [Google Scholar] [CrossRef]
- Albrecht, J.; Sidoryk-Wegrzynowicz, M.; Zielinska, M.; Aschner, M. Roles of glutamine in neurotransmission. Neuron Glia Biol. 2010, 6, 263. [Google Scholar] [CrossRef]
- Carr, E.L.; Kelman, A.; Wu, G.S.; Gopaul, R.; Senkevitch, E.; Aghvanyan, A.; Turay, A.M.; Frauwirth, K.A. Glutamine uptake and metabolism are coordinately regulated by ERK/MAPK during T lymphocyte activation. J. Immunol. 2010, 185, 1037–1044. [Google Scholar] [CrossRef] [PubMed]
- Haeussinger, D.; Schliess, F. Glutamine metabolism and signaling in the liver. Front. Biosci. 2007, 12, 371–391. [Google Scholar] [CrossRef] [PubMed]
- Watford, M. Glutamine metabolism and function in relation to proline synthesis and the safety of glutamine and proline supplementation. J. Nutr. 2008, 138, 2003S–2007S. [Google Scholar] [CrossRef]
- Lane, A.N.; Fan, T.W.-M. Regulation of mammalian nucleotide metabolism and biosynthesis. Nucleic Acids Res. 2015, 43, 2466–2485. [Google Scholar] [CrossRef]
- Caddick, M.X.; Peters, D.; Platt, A. Nitrogen regulation in fungi. Antonie Van Leeuwenhoek 1994, 65, 169–177. [Google Scholar] [CrossRef]
- Wiemann, P.; Tudzynski, B. The nitrogen regulation network and its impact on secondary metabolism and pathogenicity. In Fusarium: Genomics, Molecular and Cellular Biology; Caister Academic Press: Norfolk, UK, 2013; pp. 111–142. [Google Scholar]
- Crespo, J.L.; Powers, T.; Fowler, B.; Hall, M.N. The TOR-controlled transcription activators GLN3, RTG1, and RTG3 are regulated in response to intracellular levels of glutamine. Proc. Natl. Acad. Sci. USA 2002, 99, 6784–6789. [Google Scholar] [CrossRef]
- Camargo, A.; Llamas, Á.; Schnell, R.A.; Higuera, J.J.; González-Ballester, D.; Lefebvre, P.A.; Fernández, E.; Galván, A. Nitrate signaling by the regulatory gene NIT2 in Chlamydomonas. Plant Cell 2007, 19, 3491–3503. [Google Scholar] [CrossRef] [PubMed]
- Magasanik, B.; Kaiser, C.A. Nitrogen regulation in Saccharomyces cerevisiae. Gene 2002, 290, 1–18. [Google Scholar] [CrossRef]
- Wiame, J.-M.; Grenson, M.; Ars, H.N., Jr. Nitrogen catabolite repression in yeasts and filamentous fungi. In Advances in Microbial Physiology; Elsevier: Amsterdam, The Netherlands, 1985; Volume 26, pp. 1–88. [Google Scholar]
- Rutherford, J.C.; Chua, G.; Hughes, T.; Cardenas, M.E.; Heitman, J. A Mep2-dependent transcriptional profile links permease function to gene expression during pseudohyphal growth in Saccharomyces cerevisiae. Mol. Biol. Cell 2008, 19, 3028–3039. [Google Scholar] [CrossRef]
- Wedler, F.C.; Horn, B.R. Catalytic mechanisms of glutamine synthetase enzymes. Studies with analogs of possible intermediates and transition states. J. Biol. Chem. 1976, 251, 7530–7538. [Google Scholar] [CrossRef]
- Liaw, S.H.; Eisenberg, D. Structural model for the reaction mechanism of glutamine synthetase, based on five crystal structures of enzyme-substrate complexes. Biochemistry 1994, 33, 675–681. [Google Scholar] [CrossRef] [PubMed]
- Hirel, B.; McNally, S.F.; Gadal, P.; Sumar, N.; Stewart, G.R. Cytosolic glutamine synthetase in higher plants: A comparative immunological study. Eur. J. Biochem. 1984, 138, 63–66. [Google Scholar] [CrossRef] [PubMed]
- Hennig, S.B.; Anderson, W.B.; Ginsburg, A. Adenosine triphosphate: Glutamine synthetase adenylyltransferase of Escherichia coli: Two active molecular forms. Proc. Natl. Acad. Sci. USA 1970, 67, 1761–1768. [Google Scholar] [CrossRef]
- Jiang, P.; Mayo, A.E.; Ninfa, A.J. Escherichia coli glutamine synthetase adenylyltransferase (ATase, EC 2.7. 7.49): Kinetic characterization of regulation by PII, PII-UMP, glutamine, and α-ketoglutarate. Biochemistry 2007, 46, 4133–4146. [Google Scholar] [CrossRef]
- Al-Gharawi, A.; Moore, D. Factors affecting the amount and the activity of the glutamate dehydrogenases of Coprinus cinereus. Biochim. Biophys. Acta (BBA) Gen. Subj. 1977, 496, 95–102. [Google Scholar] [CrossRef]
- Brown, J.; Masuchi, Y.; Robb, F.; Doolittlel, W. Evolutionary relationships of bacterial and archaeal glutamine synthetase genes. J. Mol. Evol. 1994, 38, 566–576. [Google Scholar] [CrossRef] [PubMed]
- Eisenberg, D.; Gill, H.S.; Pfluegl, G.M.; Rotstein, S.H. Structure–function relationships of glutamine synthetases. Biochim. Biophys. Acta (BBA) Protein Struct. Mol. Enzymol. 2000, 1477, 122–145. [Google Scholar] [CrossRef]
- Almassy, R.J.; Janson, C.A.; Hamlin, R.; Xuong, N.; Eisenberg, D. Novel subunit—Subunit interactions in the structure of glutamine synthetase. Nature 1986, 323, 304–309. [Google Scholar] [CrossRef]
- Wyatt, K.; White, H.E.; Wang, L.; Bateman, O.A.; Slingsby, C.; Orlova, E.V.; Wistow, G. Lengsin is a survivor of an ancient family of class I glutamine synthetases re-engineered by evolution for a role in the vertebrate lens. Structure 2006, 14, 1823–1834. [Google Scholar] [CrossRef]
- Mathis, R.; Gamas, P.; Meyer, Y.; Cullimore, J.V. The presence of GSI-like genes in higher plants: Support for the paralogous evolution of GSI and GSII genes. J. Mol. Evol. 2000, 50, 116–122. [Google Scholar] [CrossRef] [PubMed]
- Dávila, G.; Lara, M.; Guzmán, J.; Mora, J. Relation between structure and function of Neurospora crassa glutamine synthetase. Biochem. Biophys. Res. Commun. 1980, 92, 134–140. [Google Scholar] [CrossRef]
- Mora, J. Glutamine metabolism and cycling in Neurospora crassa. Microbiol. Mol. Biol. Rev. 1990, 54, 293–304. [Google Scholar] [CrossRef]
- Liaw, S.-H.; Jun, G.; Eisenberg, D. Interactions of nucleotides with fully unadenylylated glutamine synthetase from Salmonella typhimurium. Biochemistry 1994, 33, 11184–11188. [Google Scholar] [CrossRef] [PubMed]
- Gunka, K.; Commichau, F.M. Control of glutamate homeostasis in Bacillus subtilis: A complex interplay between ammonium assimilation, glutamate biosynthesis and degradation. Mol. Microbiol. 2012, 85, 213–224. [Google Scholar] [CrossRef]
- Wray, L.V., Jr.; Zalieckas, J.M.; Fisher, S.H. Bacillus subtilis glutamine synthetase controls gene expression through a protein-protein interaction with transcription factor TnrA. Cell 2001, 107, 427–435. [Google Scholar] [CrossRef]
- Caggese, C.; Caizzi, R.; Barsanti, P.; Bozzetti, M.P. Mutations in the glutamine synthetase I (gsI) gene produce embryo-lethal female sterility in Drosophila melanogaster. Dev. Genet. 1992, 13, 359–366. [Google Scholar] [CrossRef]
- Häberle, J.; Görg, B.; Rutsch, F.; Schmidt, E.; Toutain, A.; Benoist, J.-F.; Gelot, A.; Suc, A.-L.; Höhne, W.; Schliess, F. Congenital glutamine deficiency with glutamine synthetase mutations. N. Engl. J. Med. 2005, 353, 1926–1933. [Google Scholar] [CrossRef]
- Bao, A.; Zhao, Z.; Ding, G.; Shi, L.; Xu, F.; Cai, H. The stable level of glutamine synthetase 2 plays an important role in rice growth and in carbon-nitrogen metabolic balance. Int. J. Mol. Sci. 2015, 16, 12713–12736. [Google Scholar] [CrossRef]
- Margelis, S.; D’Souza, C.; Small, A.J.; Hynes, M.J.; Adams, T.H.; Davis, M.A. Role of glutamine synthetase in nitrogen metabolite repression in Aspergillus nidulans. J. Bacteriol. 2001, 183, 5826–5833. [Google Scholar] [CrossRef]
- Sasaki, Y.; Kojima, A.; Shibata, Y.; Mitsuzawa, H. Filamentous invasive growth of mutants of the genes encoding ammonia-metabolizing enzymes in the fission yeast Schizosaccharomyces pombe. PLoS ONE 2017, 12, e0186028. [Google Scholar] [CrossRef]
- Teichert, S.; Schönig, B.; Richter, S.; Tudzynski, B. Deletion of the Gibberella fujikuroi glutamine synthetase gene has significant impact on transcriptional control of primary and secondary metabolism. Mol. Microbiol. 2004, 53, 1661–1675. [Google Scholar] [CrossRef]
- Talbot, N.J. On the trail of a cereal killer: Exploring the biology of Magnaporthe grisea. Annu. Rev. Microbiol. 2003, 57, 177–202. [Google Scholar] [CrossRef]
- Dagdas, Y.F.; Yoshino, K.; Dagdas, G.; Ryder, L.S.; Bielska, E.; Steinberg, G.; Talbot, N.J. Septin-mediated plant cell invasion by the rice blast fungus, Magnaporthe oryzae. Science 2012, 336, 1590–1595. [Google Scholar] [CrossRef] [PubMed]
- Howard, R.J.; Ferrari, M.A.; Roach, D.H.; Money, N.P. Penetration of hard substrates by a fungus employing enormous turgor pressures. Proc. Natl. Acad. Sci. USA 1991, 88, 11281–11284. [Google Scholar] [CrossRef]
- Kankanala, P.; Czymmek, K.; Valent, B. Roles for rice membrane dynamics and plasmodesmata during biotrophic invasion by the blast fungus. Plant Cell 2007, 19, 706–724. [Google Scholar] [CrossRef] [PubMed]
- Tullius, M.V.; Harth, G.; Horwitz, M.A. Glutamine synthetase GlnA1 is essential for growth of Mycobacterium tuberculosis in human THP-1 macrophages and guinea pigs. Infect. Immun. 2003, 71, 3927–3936. [Google Scholar] [CrossRef]
- Chen, J.; Zheng, W.; Zheng, S.; Zhang, D.; Sang, W.; Chen, X.; Li, G.; Lu, G.; Wang, Z. Rac1 is required for pathogenicity and Chm1-dependent conidiogenesis in rice fungal pathogen Magnaporthe grisea. PLoS Pathog. 2008, 4, e1000202. [Google Scholar] [CrossRef] [PubMed]
- Goswami, R.S. Targeted gene replacement in fungi using a split-marker approach. In Plant Fungal Pathogens; Springer: New York, NY, USA, 2012; pp. 255–269. [Google Scholar]
- Zhang, C.; Zong, H.; Zhuge, B.; Lu, X.; Fang, H.; Zhu, J.; Zhuge, J. Protoplast preparation and polyethylene glycol (PEG)-mediated transformation of Candida glycerinogenes. Biotechnol. Bioprocess Eng. 2016, 21, 95–102. [Google Scholar] [CrossRef]
- Qi, Z.; Wang, Q.; Dou, X.; Wang, W.; Zhao, Q.; Lv, R.; Zhang, H.; Zheng, X.; Wang, P.; Zhang, Z. MoSwi6, an APSES family transcription factor, interacts with MoMps1 and is required for hyphal and conidial morphogenesis, appressorial function and pathogenicity of Magnaporthe oryzae. Mol. Plant Pathol. 2012, 13, 677–689. [Google Scholar] [CrossRef] [PubMed]
- Wang, Y.; Pang, J.; Zheng, Y.; Jiang, P.; Gong, W.; Chen, X.; Chen, D. Genetic manipulation of the bifunctional gene, carRA, to enhance lycopene content in Blakeslea trispora. Biochem. Eng. J. 2017, 119, 27–33. [Google Scholar] [CrossRef]
- Sambrook, J.; Fritsch, E.F.; Maniatis, T. Molecular Cloning: A Laboratory Manual; Cold Spring Harbor Laboratory Press: Cold Spring Harbor, NY, USA, 1989. [Google Scholar]
- Lin, L.; Chen, X.; Shabbir, A.; Chen, S.; Chen, X.; Wang, Z.; Norvienyeku, J. A putative N-BAR-domain protein is crucially required for the development of hyphae tip appressorium-like structure and its plant infection in Magnaporthe Oryzae. Phytopathol. Res. 2019, 1, 1–15. [Google Scholar] [CrossRef]
- Livak, K.J.; Schmittgen, T.D. Analysis of relative gene expression data using real-time quantitative PCR and the 2−ΔΔCT method. Methods 2001, 25, 402–408. [Google Scholar] [CrossRef] [PubMed]
- Bruno, K.S.; Tenjo, F.; Li, L.; Hamer, J.E.; Xu, J.-R. Cellular localization and role of kinase activity of PMK1 in Magnaporthe grisea. Eukaryot. Cell 2004, 3, 1525–1532. [Google Scholar] [CrossRef]
- Dong, Y.; Li, Y.; Zhao, M.; Jing, M.; Liu, X.; Liu, M.; Guo, X.; Zhang, X.; Chen, Y.; Liu, Y. Global genome and transcriptome analyses of Magnaporthe oryzae epidemic isolate 98-06 uncover novel effectors and pathogenicity-related genes, revealing gene gain and lose dynamics in genome evolution. PLoS Pathog. 2015, 11, e1004801. [Google Scholar] [CrossRef] [PubMed]
- Langmead, B.; Salzberg, S.L. Fast gapped-read alignment with Bowtie 2. Nat. Methods 2012, 9, 357–359. [Google Scholar] [CrossRef]
- Li, B.; Dewey, C.N. RSEM: Accurate transcript quantification from RNA-Seq data with or without a reference genome. BMC Bioinform. 2011, 12, 323. [Google Scholar] [CrossRef] [PubMed]
- Love, M.I.; Huber, W.; Anders, S. Moderated estimation of fold change and dispersion for RNA-seq data with DESeq2. Genome Biol. 2014, 15, 550. [Google Scholar] [CrossRef]
- McGinnis, S.; Madden, T.L. BLAST: At the core of a powerful and diverse set of sequence analysis tools. Nucleic Acids Res. 2004, 32, W20–W25. [Google Scholar] [CrossRef]
- Liu, W.; Xie, Y.; Ma, J.; Luo, X.; Nie, P.; Zuo, Z.; Lahrmann, U.; Zhao, Q.; Zheng, Y.; Zhao, Y. IBS: An illustrator for the presentation and visualization of biological sequences. Bioinformatics 2015, 31, 3359–3361. [Google Scholar] [CrossRef]
- Marroquin-Guzman, M.; Wilson, R.A. GATA-dependent glutaminolysis drives appressorium formation in Magnaporthe oryzae by suppressing TOR inhibition of cAMP/PKA signaling. PLoS Pathog. 2015, 11, e1004851. [Google Scholar] [CrossRef] [PubMed]
- Kim, S.; Park, S.-Y.; Kim, K.S.; Rho, H.-S.; Chi, M.-H.; Choi, J.; Park, J.; Kong, S.; Park, J.; Goh, J. Homeobox transcription factors are required for conidiation and appressorium development in the rice blast fungus Magnaporthe oryzae. PLoS Genet. 2009, 5, e1000757. [Google Scholar] [CrossRef] [PubMed]
- de Jong, J.C.; McCormack, B.J.; Smirnoff, N.; Talbot, N.J. Glycerol generates turgor in rice blast. Nature 1997, 389, 244. [Google Scholar] [CrossRef]
- Lussier, M.; White, A.-M.; Sheraton, J.; di Paolo, T.; Treadwell, J.; Southard, S.B.; Horenstein, C.I.; Chen-Weiner, J.; Ram, A.F.; Kapteyn, J.C. Large scale identification of genes involved in cell surface biosynthesis and architecture in Saccharomyces cerevisiae. Genetics 1997, 147, 435–450. [Google Scholar] [CrossRef] [PubMed]
- Ram, A.F.; Wolters, A.; Hoopen, R.T.; Klis, F.M. A new approach for isolating cell wall mutants in Saccharomyces cerevisiae by screening for hypersensitivity to calcofluor white. Yeast 1994, 10, 1019–1030. [Google Scholar] [CrossRef]
- Bickle, M.; Delley, P.A.; Schmidt, A.; Hall, M.N. Cell wall integrity modulates RHO1 activity via the exchange factor ROM2. EMBO J. 1998, 17, 2235–2245. [Google Scholar] [CrossRef] [PubMed]
- Shimizu, J.; Yoda, K.; Yamasaki, M. The hypo-osmolarity-sensitive phenotype of the Saccharomyces cerevisiae hpo2 mutant is due to a mutation in PKC1, which regulates expression of β-glucanase. Mol. Gen. Genet. MGG 1994, 242, 641–648. [Google Scholar] [CrossRef]
- Wood, P.J.; Fulcher, R. Dye interactions. A basis for specific detection and histochemistry of polysaccharides. J. Histochem. Cytochem. 1983, 31, 823–826. [Google Scholar] [CrossRef]
- Yin, Z.; Tang, W.; Wang, J.; Liu, X.; Yang, L.; Gao, C.; Zhang, J.; Zhang, H.; Zheng, X.; Wang, P. Phosphodiesterase MoPdeH targets MoMck1 of the conserved mitogen-activated protein (MAP) kinase signalling pathway to regulate cell wall integrity in rice blast fungus Magnaporthe oryzae. Mol. Plant Pathol. 2016, 17, 654–668. [Google Scholar] [CrossRef]
- Shimizu, J.; Okumura, Y.; Yoda, K.; Yamasaki, M. A glutamine synthetase mutant of Saccharomyces cerevisiae shows defect in cell wall. J. Gen. Appl. Microbiol. 1997, 43, 157–162. [Google Scholar] [CrossRef] [PubMed]
- Kim, K.-H.; Willger, S.D.; Park, S.-W.; Puttikamonkul, S.; Grahl, N.; Cho, Y.; Mukhopadhyay, B.; Cramer, R.A., Jr.; Lawrence, C.B. TmpL, a transmembrane protein required for intracellular redox homeostasis and virulence in a plant and an animal fungal pathogen. PLoS Pathog. 2009, 5, e1000653. [Google Scholar] [CrossRef]
- Guo, M.; Guo, W.; Chen, Y.; Dong, S.; Zhang, X.; Zhang, H.; Song, W.; Wang, W.; Wang, Q.; Lv, R. The basic leucine zipper transcription factor Moatf1 mediates oxidative stress responses and is necessary for full virulence of the rice blast fungus Magnaporthe oryzae. Mol. Plant Microbe Interact. 2010, 23, 1053–1068. [Google Scholar] [CrossRef] [PubMed]
- Fernandez, J.; Yang, K.T.; Cornwell, K.M.; Wright, J.D.; Wilson, R.A. Growth in rice cells requires de novo purine biosynthesis by the blast fungus Magnaporthe oryzae. Sci. Rep. 2013, 3, 2398. [Google Scholar] [CrossRef] [PubMed]
- Yang, J.; Zhao, X.; Sun, J.; Kang, Z.; Ding, S.; Xu, J.-R.; Peng, Y.-L. A novel protein Com1 is required for normal conidium morphology and full virulence in Magnaporthe oryzae. Mol. Plant Microbe Interact. 2010, 23, 112–123. [Google Scholar] [CrossRef]
- Harth, G.; Clemens, D.L.; Horwitz, M.A. Glutamine synthetase of Mycobacterium tuberculosis: Extracellular release and characterization of its enzymatic activity. Proc. Natl. Acad. Sci. USA 1994, 91, 9342–9346. [Google Scholar] [CrossRef]
- Dunn-Coleman, N.S.; Garrett, R.H. The role of glutamine synthetase and glutamine metabolism in nitrogen metabolite repression, a regulatory phenomenon in the lower eukaryote Neurospora crassa. Mol. Gen. Genet. MGG 1980, 179, 25–32. [Google Scholar] [CrossRef]
- Shatters, R.; Liu, Y.; Kahn, M. Isolation and characterization of a novel glutamine synthetase from Rhizobium meliloti. J. Biol. Chem. 1993, 268, 469–475. [Google Scholar] [CrossRef]
- Adams, T.H.; Wieser, J.K.; Yu, J.-H. Asexual sporulation in Aspergillus nidulans. Microbiol. Mol. Biol. Rev. 1998, 62, 35–54. [Google Scholar] [CrossRef]
- Garzia, A.; Etxebeste, O.; Herrero-Garcia, E.; Fischer, R.; Espeso, E.A.; Ugalde, U. Aspergillus nidulans FlbE is an upstream developmental activator of conidiation functionally associated with the putative transcription factor FlbB. Mol. Microbiol. 2009, 71, 172–184. [Google Scholar] [CrossRef]
- Kikuma, T.; Arioka, M.; Kitamoto, K. Autophagy during conidiation and conidial germination in filamentous fungi. Autophagy 2007, 3, 128–129. [Google Scholar] [CrossRef]
- Timberlake, W.E. Temporal and spatial controls of Aspergillus development. Curr. Opin. Genet. Dev. 1991, 1, 351–357. [Google Scholar] [CrossRef]
- Yan, X.; Que, Y.; Wang, H.; Wang, C.; Li, Y.; Yue, X.; Ma, Z.; Talbot, N.J.; Wang, Z. The MET13 methylenetetrahydrofolate reductase gene is essential for infection-related morphogenesis in the rice blast fungus Magnaporthe oryzae. PLoS ONE 2013, 8, e76914. [Google Scholar]
- Du, Y.; Zhang, H.; Hong, L.; Wang, J.; Zheng, X.; Zhang, Z. Acetolactate synthases MoIlv2 and MoIlv6 are required for infection-related morphogenesis in Magnaporthe oryzae. Mol. Plant Pathol. 2013, 14, 870–884. [Google Scholar] [CrossRef]
- Khan, K.; Hardy, G.; McElroy, B.; Elia, M. The stability of L-glutamine in total parenteral nutrition solutions. Clin. Nutr. 1991, 10, 193–198. [Google Scholar] [CrossRef]
- Dulermo, T.; Bligny, R.; Gout, E.; Cotton, P. Amino acid changes during sunflower infection by the necrotrophic fungus B. cinerea. Plant Signal. Behav. 2009, 4, 859–861. [Google Scholar] [CrossRef] [PubMed]
- Lahrmann, U.; Ding, Y.; Banhara, A.; Rath, M.; Hajirezaei, M.R.; Döhlemann, S.; von Wirén, N.; Parniske, M.; Zuccaro, A. Host-related metabolic cues affect colonization strategies of a root endophyte. Proc. Natl. Acad. Sci. USA 2013, 110, 13965–13970. [Google Scholar] [CrossRef]
- Chandra, H.; Basir, S.F.; Gupta, M.; Banerjee, N. Glutamine synthetase encoded by glnA-1 is necessary for cell wall resistance and pathogenicity of Mycobacterium bovis. Microbiology 2010, 156, 3669–3677. [Google Scholar] [CrossRef] [PubMed]
- Ponton, J. The fungal cell wall and the mechanism of action of anidulafungin. Rev. Iberoam. Micol. 2008, 25, 78–82. [Google Scholar] [PubMed]
- Gow, N.A.; Latge, J.-P.; Munro, C.A. The fungal cell wall: Structure, biosynthesis, and function. Microbiol. Spectr. 2017, 5, 267–292. [Google Scholar]
- Agustinho, D.P.; Miller, L.C.; Li, L.X.; Doering, T.L. Peeling the onion: The outer layers of Cryptococcus neoformans. Mem. Inst. Oswaldo Cruz 2018, 113, e180040. [Google Scholar] [CrossRef] [PubMed]
- Aguirre, J.; Ríos-Momberg, M.; Hewitt, D.; Hansberg, W. Reactive oxygen species and development in microbial eukaryotes. Trends Microbiol. 2005, 13, 111–118. [Google Scholar] [CrossRef] [PubMed]
- Gessler, N.N.; Aver’yanov, A.A.; Belozerskaya, T. Reactive oxygen species in regulation of fungal development. Biochem. (Moscow) 2007, 72, 1091–1109. [Google Scholar] [CrossRef]
- Song, W.; Dou, X.; Qi, Z.; Wang, Q.; Zhang, X.; Zhang, H.; Guo, M.; Dong, S.; Zhang, Z.; Wang, P. R-SNARE homolog MoSec22 is required for conidiogenesis, cell wall integrity, and pathogenesis of Magnaporthe oryzae. PLoS ONE 2010, 5, e13193. [Google Scholar] [CrossRef]

| Amino Acid | p-Value | Guy11 | ΔMogln2 | ||
|---|---|---|---|---|---|
| Mean | Mean | ||||
| (μg/g) SD | (μg/g) SD | ||||
| Alanine | 0.004 | 2158.11 | 41.42232 | 3521.255 | 111.47538 |
| Serine | 0.015 | 394.285 | 88.46613 | 911.845 | 13.73908 |
| Proline | 0.01 | 234.075 | 22.90319 | 1054.775 | 116.4817 |
| Valine | 0.008 | 399.47 | 1.24451 | 1125.905 | 90.12076 |
| Isoleucine | 0.014 | 150.165 | 24.71338 | 604.355 | 73.88559 |
| Threonine | 0.03 | 412.59 | 9.48937 | 2922.265 | 405.98536 |
| Aspartate | 0.097 | 287.76 | 51.36424 | 503.8 | 89.35001 |
| Leucine | 0 | 219.82 | 3.73352 | 880.38 | 7.43876 |
| Asparagine | 0.012 | 119.015 | 35.65939 | 421.79 | 31.09856 |
| Lysine | 0.038 | 2444.65 | 479.2487 | 17,505.03 | 4272.45938 |
| Glutamate | 0.024 | 1731.585 | 84.53462 | 4348.05 | 583.39138 |
| Methionine | 0.026 | 50.34 | 3.6911 | 186.5 | 31.72081 |
| Histidine | 0.094 | 474.54 | 36.44428 | 1734.325 | 585.7319 |
| Phenylalanine | 0.007 | 4.1295 | 4.1295 | 460.365 | 38.33226 |
| Arginine | 0.282 | 2692.36 | 310.1512 | 4231.13 | 1456.97938 |
| Tryptophan | 0.002 | 50.755 | 0.3182 | 241.79 | 12.37437 |
| Tyrosine | 0.064 | 271.06 | 60.99503 | 1841.21 | 589.82605 |
Publisher’s Note: MDPI stays neutral with regard to jurisdictional claims in published maps and institutional affiliations. |
© 2021 by the authors. Licensee MDPI, Basel, Switzerland. This article is an open access article distributed under the terms and conditions of the Creative Commons Attribution (CC BY) license (https://creativecommons.org/licenses/by/4.0/).
Share and Cite
Aron, O.; Wang, M.; Lin, L.; Batool, W.; Lin, B.; Shabbir, A.; Wang, Z.; Tang, W. MoGLN2 Is Important for Vegetative Growth, Conidiogenesis, Maintenance of Cell Wall Integrity and Pathogenesis of Magnaporthe oryzae. J. Fungi 2021, 7, 463. https://doi.org/10.3390/jof7060463
Aron O, Wang M, Lin L, Batool W, Lin B, Shabbir A, Wang Z, Tang W. MoGLN2 Is Important for Vegetative Growth, Conidiogenesis, Maintenance of Cell Wall Integrity and Pathogenesis of Magnaporthe oryzae. Journal of Fungi. 2021; 7(6):463. https://doi.org/10.3390/jof7060463
Chicago/Turabian StyleAron, Osakina, Min Wang, Lianyu Lin, Wajjiha Batool, Birong Lin, Ammarah Shabbir, Zonghua Wang, and Wei Tang. 2021. "MoGLN2 Is Important for Vegetative Growth, Conidiogenesis, Maintenance of Cell Wall Integrity and Pathogenesis of Magnaporthe oryzae" Journal of Fungi 7, no. 6: 463. https://doi.org/10.3390/jof7060463
APA StyleAron, O., Wang, M., Lin, L., Batool, W., Lin, B., Shabbir, A., Wang, Z., & Tang, W. (2021). MoGLN2 Is Important for Vegetative Growth, Conidiogenesis, Maintenance of Cell Wall Integrity and Pathogenesis of Magnaporthe oryzae. Journal of Fungi, 7(6), 463. https://doi.org/10.3390/jof7060463

